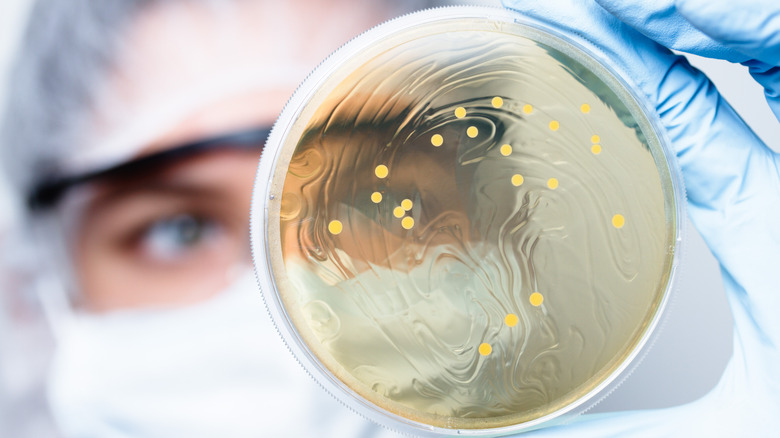
Scientist holding Lactobacillus colony

The Ultimate Guide To Pickles
We may receive a commission on purchases made from links.
Whether you love them or hate them, you have to respect the pickle's longevity. Pickling is a culinary technique that uses anaerobic fermentation or vinegar to preserve foods. The technique originated with the ancient Mesopotamians around 2400 B.C., per the Journal of Food Science and Technology. While any number of food items can be pickled, the one most commonly associated with the process is the cucumber. According to the same publication, pickled cucumbers — known simply as pickles — were first produced around 2030 B.C., when cucumbers reached Mesopotamia via the Indian subcontinent.
During their 4,000-year history, pickles have spread from the Himalayan belt to countries all around the world, per History. They have become a favorite food of many notable figures, featured in famous literature, and facilitated the rise of empires.
Today, pickles are so much more than the simple slices that sit atop our burgers. They continue to play an important role in the life of many populations. In fact, Americans eat an average of 9 pounds of pickles each year (via United States Department of Agriculture). In the contemporary world, pickles are used as flavor boosters, food waste reducers, and athletic aids.
Pickling is a complex scientific process
Pickling is a complex scientific process that delays the spoilage of food. It does this by inhibiting or killing bacteria and any other undesirable microorganisms that would begin breaking down the food (per Food Preservation).
There are two distinct types of pickles: fermented and vinegar-pickled. Fermented pickles are produced through a process called lactic acid fermentation, an ancient practice that the Mesopotamians used to make their pickles 4000 years ago (via the Journal of Food Science and Technology). Lactic acid fermentation works because Lactobacillus — lactic acid bacteria that are found on nearly all organic matter — are salt and acid tolerant (via the Journal of Functional Foods). This means that cucumbers submerged in brine will transform from sweet and soft to crunchy and acidic by Lactobacillus. At the same time, bacteria that would spoil the cucumbers are inhibited by the salt content first, then by the acid byproduct produced by Lactobacillus.
By contrast, vinegar pickling begins with combining and boiling salt, water, and vinegar and submerging cucumbers in the liquid. The vegetables become preserved thanks to the acidic content of the vinegar, rather than Lactobacillus or a starter culture being used. As such, the pickles are rapidly protected from food-spoiling bacteria without the need for fermentation to occur (via Gardening Know How).
Pickles have been a long prized from of food preservation
Although pickles are delicious, they were not traditionally prized for their flavor. Rather, pickles became an integral part of many populations' diets because they were an effective means of preserving food. In a world before refrigeration, and when food sources were more volatile than they are today, the ability to preserve food from bountiful times was vital for survival, as noted in Food Preservation in Developing Countries: Challenges and Solutions.
The YIVO Institute for Jewish Research reports that lacto-fermented pickles played a critical role in sustaining Jewish communities through the harsh winters of the 19th and early 20th centuries in Europe. The institute states that pickles provided Lithuanian Jewish communities with vital calories and, even more importantly, a source of vitamin C that was extremely hard to come by in months when fresh, green vegetables were scarce.
Chronic vitamin C deficiency was also a worry for many individuals who sailed on long voyages during the Age of Discovery. Scurvy, a disease caused by chronic vitamin C deficiency, was the cause of death for nearly 2 million sailors between the 16th and 18th centuries (per U.S. Naval Institute).
Before the discovery of scurvy's causes, many preventive methods were tried with varying degrees of success, as highlighted by Science History Institute. Fortunately, lacto-fermented pickles protected many crews during their voyages, with Christopher Columbus even stocking his ships with pickles when he sailed to the Americas (via United States Department of Agriculture).
They have been celebrated throughout history by various figures
While pickles' nutritional benefits are undoubtedly important, the food product has been celebrated throughout history for a number of reasons. Cleopatra was one of the most notable early figures who touted the benefits of fermented cucumbers. As reported by History, the famous Egyptian queen believed that eating pickles contributed to her renowned beauty. According to the same source, Julius Caesar also added pickles to the Roman army's diet during this time period.
This salty snack also had a large influence on human society thanks to the food product's continued associations with art, culture, and literature. For example, pickles were frequently mentioned by famous playwright William Shakespeare, particularly in his play "The Tempest," where he coined the term "in a pickle" (per No Sweat Shakespeare). The pickle's association with popular culture is still seen today. This has most recently taken the form of Seth Rogan's 2020 film "An American Pickle" and Season 3, Episode 3 of the hit TV show "Rick and Morty."
Pickles differ in their probiotic qualities
As we have seen, pickles are either lacto-fermented or vinegar-based. Due to the process of fermentation, lacto-fermented pickles are extremely nutritious and have been associated with numerous health benefits. This is because, as the Journal of Dairy Science reports, the various strains of Lactobacillus found in fermented pickles have been shown to suppress cancer, improve digestion, and increase the gastrointestinal tract's resistance to disease.
On the other hand, vinegar pickles contain fewer nutritional benefits than their lacto-fermented counterparts (per Ixcela). This is because the probiotic bacteria that are the root of so many lacto-fermented pickles' health benefits are not present in vinegar-based pickles. Furthermore, store-bought vinegar pickles tend to feature more additives, as explained by chef and nutrition counselor Amy Spindel. She explained to Eat This, Not That, that vinegar pickles bought from a store tend to have additional preservatives, such as sodium benzoate, calcium chloride, and potassium chloride. They may also include artificial colors.
New York City has a long relationship with pickles
As reported by History, Americans' love for pickles can be traced back to the mid-17th century when Dutch farmers began growing cucumbers in New York. During the 19th and 20th centuries, many Eastern European Jews arrived in New York, fleeing political upheaval and persecution in central and eastern Europe (per Library of Congress). The arrival of this population, which had a long history of creating pickles, catapulted the food to prominence across the city, state, and country.
In New York City, the majority of Jewish immigrants settled in the Lower East Side where Jewish culture underwent a renaissance. As the culture in the city bloomed, traditional foods were made and sold in large quantities. The most prominent of these perhaps is the kosher dill pickle, a fermented pickle flavored with both dill and garlic (per Livestrong).
During the 19th and 20th centuries, around 80 Jewish pickle pushcart vendors dominated Essex Street on the Lower East Side, earning the street the nickname "Pickle Alley" (via Untapped Cities). The pickles were an extremely popular street food with many vendors going on to open stores of their own. However, the popularity of these snacks as street food has waned in recent decades. This fact, combined with rising rent and other social, economic, and cultural factors, has meant there is only one pickle store currently open on Essex Street, The Pickle Guys.
Some athletes swear by pickle juice
The ancient Romans believed that eating pickles would make their army stronger (per History). Even today, there is a steadily growing consensus that pickle juice — or brine — can be beneficial for those seriously exerting themselves, with athletes, in particular, singing the praises of this salty liquid.
At the 2019 Australian Open, two tennis stars, Frances Tiafoe and Daniil Medvedev, were seen drinking pickle juice (via BBC). Speaking to the BBC, Mayur Ranchordas, a doctor who lectures on sports nutrition, explained why athletes are downing shots of pickle juice. He notes that pickle juice contains potassium, sodium, and vinegar. When the juice is consumed, it replaces the salts lost from sweat and helps to hydrate the body. This can either prevent cramping or stops it 40% faster than drinking water alone.
Despite some news outlets labeling pickle juice a trend, drinking it has been a practice employed by athletes for decades, as noted by Daily Mail. This is perhaps no better exemplified than by the NFL game that occurred between the Philadelphia Eagles and the Dallas Cowboys in 2000. In an interview after the game, numerous players from the Eagles highlighted how pickle juice had helped them survive the brutal 109-degree heat and enabled their victory (per NBC Sports).
Other flavors are boosted by the presence of pickles
The addition of pickles on burgers and sandwiches is the bane of a pickle hater's life. However, the almost customary inclusion of them is due to the fact that they're proven to improve the taste, texture, and appearance of these dishes.
As reported by Daily Mail, researchers from the University of Oxford concluded that the acidity of pickles cuts through these umami-rich foods and provides the ultimate "oral-somatosensory experience." The Daily Mail also notes that despite scientific evidence, the majority of Britons still report removing the pickle before eating their burgers.
Any deli goer worth their salt will be quick to point out that pickles are not only served in sandwiches and burgers but also alongside them. This, as reported by Mental Floss, is because pickles are fantastic palate cleansers. Their inherent acidity allows for rich flavors to be wiped from an individual's tongue, meaning they can fully taste whatever they chew next. The power of pickled, acidic foods to cleanse palates has long been established, as demonstrated by the tradition of serving pickled ginger between courses at sushi restaurants (per MasterClass).
The artisan pickle scene is booming
While the days of a bustling Pickle Alley might be long gone, the demand for local, artisanal pickles remains. As prominent journalist Adam Davidson explains in an article for The New York Times, this phenomenon was born out of the United State's middle class. Many of these individuals are now pursuing careers in an area they enjoy, including selling premium goods to other affluent individuals.
Examples of successful pickle businesses abound throughout the United States, from Pittsburgh Pickle Company to Philadelphia's Fishtown Pickle Project. The widespread success of these artisan pickle producers — and other artisan food producers — is partly thanks to consumer behavior shifting towards the prioritization of healthy, natural foods (via Food Processing). Artisans are also having success as a result of the growing number of digital platforms that allow them to market and sell their products to a wider customer base (per Speciality Food Magazine).
Fortunately, these behavioral shifts and technological advances have come at a time when the U.S specialty food market is booming, having grown 7.4% from 2020 to 2021 (via the Specialty Food Association). When this outlook is combined with an extremely positive market prediction for the pickle market in general (per Market Data Forecast), it seems that the artisan pickle industry will continue to thrive over the coming years.
Heinz's longest running marketing scheme is pickle themed
To many people, the name Heinz is synonymous with baked beans and ketchup. However, one of the brand's original products that predate both of these is pickles, which were sold by the company as early as 1869 (via Heinz). The Heinz pickle has lived on thanks to an ingenious and incredibly successful marketing scheme.
The Heinz pickle pin was launched in 1893 at Chicago's World Fair. The simple gift was initially dreamed up by H. J. Heinz as a means of luring people to his company's stall, which was located out of the way on the second floor, as noted in Positively Pittsburgh. Throughout the event, over 1 million pins were given away, and thousands of individuals went on to proudly wear the Heinz pickle pin, attaching it to pocket watches, brooches, and lapels (via Senator John Heinz History Center). The pin has remained successful over the years, with many individuals still choosing to wear it today. The fact that this marketing scheme is still running more than 100 years after it launched makes it one of the longest-running marketing campaigns in the world (via Chicago Tribune). During this time, an estimated 100 million pickle pins have been distributed globally, indicating the enormous soft spot humans have for the humble pickle.
Pickles can be flavored with a number of ingredients
While dill is perhaps the most ubiquitous ingredient used to flavor pickles, it need not be the only one. An article by MasterClass suggests a variety of ingredients that can be used during the pickling process, including black peppercorns, whole garlic cloves, and bay leaves.
Yet, even these flavorings are seen as mundane by some, thanks in part to an unusual trend that started in the southern states. Kool-Aid flavored pickles, a viral Tik-Tok pickle variation, have become increasingly popular around the United States, although they understandably remain divisive. As reported by Thrillist, making them is as simple as adding the instant Kool-aid powder to the pickle brine. In a few days, the resulting pickles are bright red or blue in color and have a unique, sweet, and savory taste.
As the The New York Times reports, the role can now even be reversed. Pickle flavoring is also being used to give a variety of food products the snack's distinct, briny flavor. Explaining the trend in dill pickle-flavored falafel and pickle pizza is Bret Thorn, a food writer and editor, who says, "It's a tanginess that appeals to a lot of consumers, especially younger ones. And I don't think people say, 'I've tried a lot of bold flavors, now I'm going to go back to blander ones.'"
Pickles can be made with more than just cucumbers
While pickled cucumbers are typically the first pickled vegetable that comes to mind, there are numerous types available. Many pickled foods have a cultural heritage as rich and complex as that of pickled cucumbers. Chief amongst these is cabbage, with numerous pickled variations being made around the world.
Kimchi originated more than 3,000 years ago as a way to preserve vegetables to eat during Korea's cold winter months (via BBC). People in Eastern Europe and Russia had the same approach to avoiding starvation. They fermented cabbage, beets, carrots, and peppers to make sauerkraut, which was mixed in a soup or served as a side salad (per Revolution Fermentation).
Societies around the world, such as Ireland, have also been pickling meat and fish for centuries (per the The Irish Times). These ancient food products are having a renaissance thanks to premier restaurants, such as Noma, a hot spot in Copenhagen. The restaurant uses pickled foods to access an array of flavors and textures not usually seen in the contemporary culinary sector (via Wired).
Pickling can reduce food waste
Modern, globalized food networks ensure that fresh food is available year-round for most of the world's population. This means that the need for preserved, pickled goods in order to survive the leaner winter months does not widely apply. However, contemporary food supply chains have created a host of new issues for our societies, with the most pertinent being extremely high levels of food waste.
Feeding America reports that 108 billion pounds of food are wasted in the United States every year. This amounts to 40% of all the food in America. Furthermore, more than 6% of the world's greenhouse gas emissions arise solely from global food waste (per Our World in Data). Fortunately, a solution to at least some of this waste might be found in the ancient process of pickling. This is because vinegar-based pickling and lacto-fermentation offer food scraps a second lease at life. Pickling goods extends the shelf lives of products and allows us to utilize previously unusable foodstuffs, such as pineapple skins and watermelon rinds (per Grundig). All of this suggests that this ancient practice may yet pave the way for the future of our civilization.